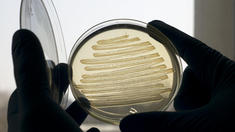

| FINANZEN - BÖRSE + MÄRKTE | ||||||||||||||||||||||||
|
||||||||||||||||||||||||
| FINANZEN - AKTIEN | ||||||||||||||||||||||||||||
|
||||||||||||||||||||||||||||
| FINANZEN - ZERTIFIKATE | ||||||||||||||||||||||||||||
|
||||||||||||||||||||||||||||
| FINANZEN - FONDS + ETF | ||||||||||||||||||||||||||||
|
||||||||||||||||||||||||||||
| FINANZEN - ROHSTOFFE + DEVISEN | ||||||||||||||||||||||||||||
|
||||||||||||||||||||||||||||
| FINANZEN - IMMOBILIEN | ||||||||||||||||||||||||||||
|
||||||||||||||||||||||||||||
| FINANZEN - VORSORGE + VERSICHERUNG | ||||||||||||||||||||||||
|
||||||||||||||||||||||||
| FINANZEN - RECHT + STEUERN | ||||||||||||||||||||||||||||
|
||||||||||||||||||||||||||||
| UNTERNEHMEN - INDUSTRIE | ||||||||||||||||||||||||||||
|
||||||||||||||||||||||||||||
| UNTERNEHMEN - BANKEN | ||||||||||||||||||||||||||||
|
||||||||||||||||||||||||||||
| UNTERNEHMEN - HANDEL + DIENSTLEISTER | ||||||||||||||||||||||||||||
|
||||||||||||||||||||||||||||
| UNTERNEHMEN - IT + MEDIEN | ||||||||||||||||||||||||||||
|
||||||||||||||||||||||||||||
| UNTERNEHMEN - MITTELSTAND | ||||||||||||||||||||||||
|
||||||||||||||||||||||||
| UNTERNEHMEN - MANAGEMENT | ||||||||||||||||||||||||||
|
||||||||||||||||||||||||||
| POLITIK - DEUTSCHLAND | ||||||||||||||||||||||||||||
|
||||||||||||||||||||||||||||
| POLITIK - INTERNATIONAL | ||||||||||||||||||||||||||||
|
||||||||||||||||||||||||||||
| POLITIK - KONJUNKTUR | ||||||||||||||||||||||||||||
|
||||||||||||||||||||||||||||
| POLITIK - ÖKONOMIE | ||||||||||||||||||||||||
|
||||||||||||||||||||||||
| TECHNOLOGIE - IT + TELEKOMMUNIKATION | ||||||||||||||||||||||||
|
||||||||||||||||||||||||
| TECHNOLOGIE - FORSCHUNG + MEDIZIN | ||||||||||||||||||||||||||
|
||||||||||||||||||||||||||
| TECHNOLOGIE - ENERGIE + UMWELT | ||||||||||||||||||||||||||||
|
||||||||||||||||||||||||||||
| AUTO - NACHRICHTEN | ||||||||||||||||||||||||||||
|
||||||||||||||||||||||||||||
| AUTO - RATGEBER + SERVICE | ||||||||||||||||||||||||||||
|
||||||||||||||||||||||||||||
| AUTO - TEST + TECHNIK | ||||||||||||||||||||||||||||
|
||||||||||||||||||||||||||||
| MEINUNG - KOMMENTARE | ||||||||||||||||||||||||||||
|
||||||||||||||||||||||||||||
| MEINUNG - KOLUMNEN | ||||||||||||||||||||
|
||||||||||||||||||||
| MEINUNG - GASTBEITRÄGE | ||||||||||||||||||||||||||||
|
||||||||||||||||||||||||||||
| MEINUNG - PRESSESCHAU | ||||||||||||||||||||||||||||
|
||||||||||||||||||||||||||||
| SPORT - FUSSBALL | ||||||||||||||||||||||||||||
|
||||||||||||||||||||||||||||
| SPORT - MOTORSPORT | ||||||||||||||||||||||||||||
|
||||||||||||||||||||||||||||
| SPORT - SONSTIGE SPORTARTEN | ||||||||||||||||||||||||||||
|
||||||||||||||||||||||||||||
| PANORAMA - AUS ALLER WELT | ||||||||||||||||||||||||||||
|
||||||||||||||||||||||||||||
| PANORAMA - KULTUR + LITERATUR | ||||||||||||||||||||||||||||
|
||||||||||||||||||||||||||||
| PANORAMA - KUNSTMARKT | ||||||||||||||||||||||||||
| ||||||||||||||||||||||||||